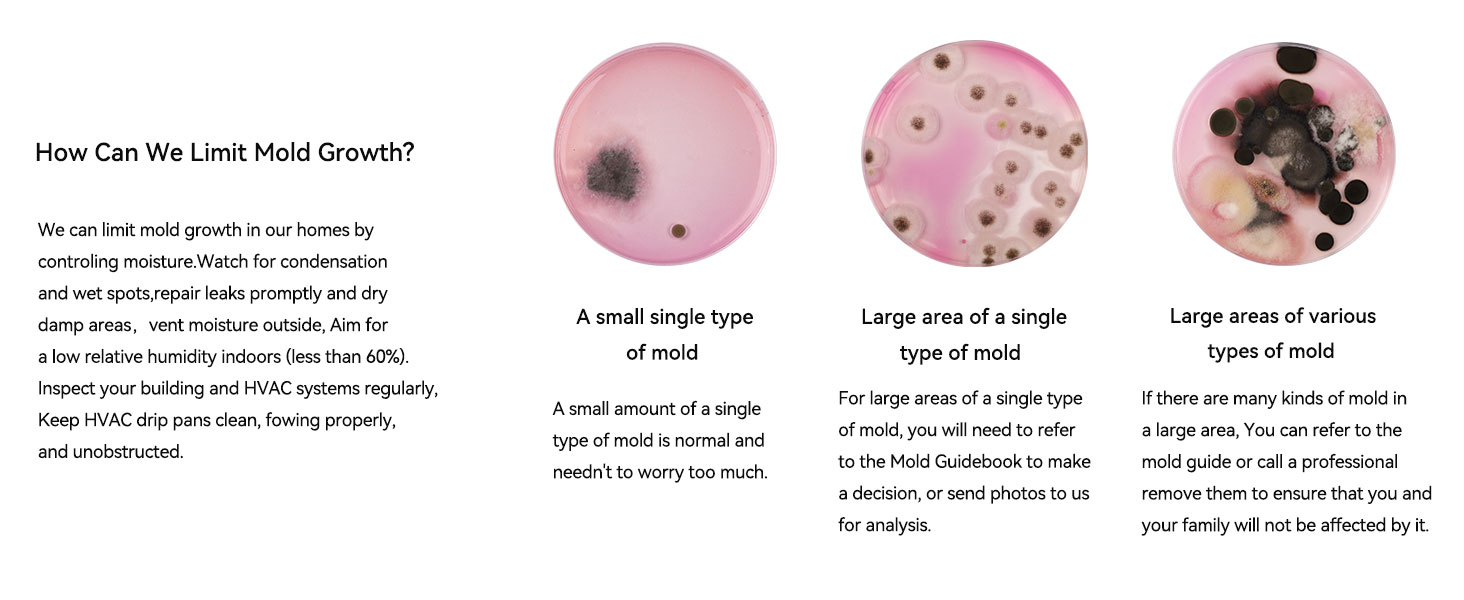
6

Price: $23.99
(as of Feb 28, 2025 19:03:34 UTC – Details)
Product Description


1 Test Room Air
2 Test Moldy Surfaces
3 Test HVAC System
Mold Testing Kit – This DIY home mold test kit includes 6 individual tests,enough cotton-tipped swabs, enclosed plastic bag,disposable gloves,label sticker,detailed identification and removal guide.
User-Friendly Design – This home air mold test kit is simple and easy to use for anyone without the need for professional assistance.Ideal for testing for mold at multiple areas,such as walls, showers, cars, sinks, HVAC systems, indoor air and other moldy and moist physical surfaces.
Fast and Reliable Mold Detector -This mold test quick and effectively detects mold in living spaces areas. You can easily identify and understand the type of mold present in your home, enabling prompt and effective action. This is especially crucial for families with kids or individuals with allergies and respiratory issues.
Best for Home – Complete kit for easy mold testing at home without needing to prepare anything else. With 6 tests included, it offers great value, allowing regular monitoring without the high costs.
Mold Guide and Free Laboratory Analysis:The Mold Guide helps you identify common types of mold and teaches you how to remove it. We also provide free laboratory analysis. You only need to send us photos of the mold, no need to mail it, and professionals will analyze it for you 24 hours a day.
User Reviews
Be the first to review “Mold Test Kit for Home – 6 Individual Detection Tests,Home Surfaces, HVAC System,Indoor Air Quality Testing Kits,DIY Mold Detector Includes Detailed Mold Identification Guide”
$23.99

There are no reviews yet.